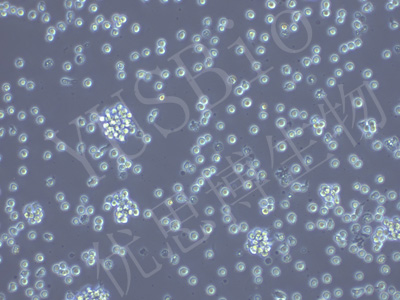

产品中心
产品中心
-

H4 人脑神经胶质瘤细胞(STR鉴定)
货号:YLH520规格: 1*10^6 -

PA-1 人卵巢畸胎瘤细胞(STR鉴定)
货号:YLH521规格: 1*10^6 -

GP2d 人结肠癌细胞(STR鉴定)
货号:YLH522规格: 1*10^6 -

UPCI-SCC-090 人舌鳞癌细胞(STR鉴定)
货号:YLH523规格: 1*10^6 -

SAS 人舌鳞状癌细胞(STR鉴定)
货号:YLH524规格: 1*10^6 -

SK-N-DZ 人神经母细胞瘤细胞(STR鉴定)
货号:YLH525规格: 1*10^6 -
LCL 721.221 人B淋巴细胞母细胞(STR鉴定)
货号:YLH526规格: 1*10^6 -

OPM2 人骨髓瘤细胞(STR鉴定)
货号:YLH527规格: 1*10^6 -

Detroit 562 人咽头癌胸水转移细胞(STR鉴定)
货号:YLH528规格: 1*10^6 -

IM-9 人B淋巴细胞(STR鉴定)
货号:YLH529规格: 1*10^6 -

M-07e 人巨细胞白血病细胞(STR鉴定)
货号:YLH530规格: 1*10^6 -

AMO1 人多发性骨髓瘤细胞(STR鉴定)
货号:YLH531规格: 1*10^6
在线咨询
Online consultation

关注微信公众号


